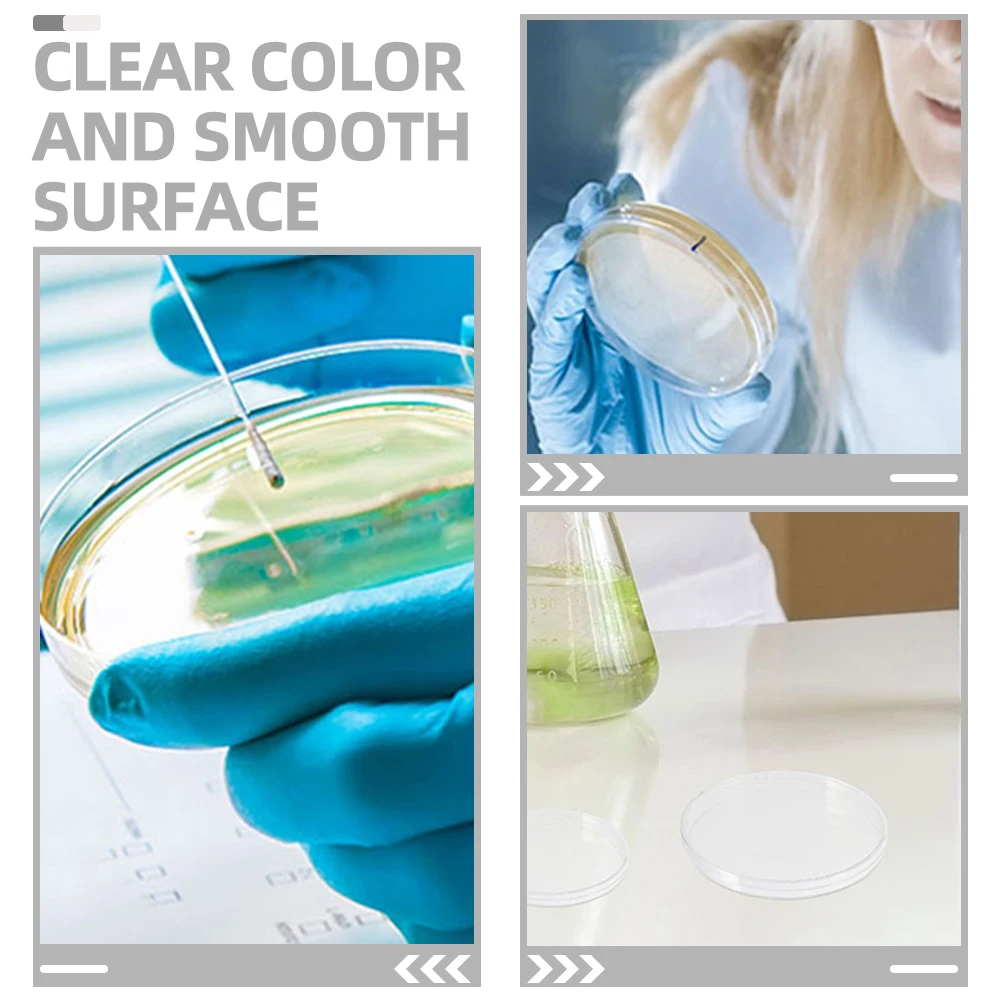
20 Pcs Petri Dish Empty Culture Dishes with Lids Plastic Laboratory Plates Chemistry

Комплект щеток стеклоочистителя HUOYE Y8-Honda City 3A2\3A3 1996-2003, Y8
Description
В этой карточке товара вы можете приобрести гибридную силиконовую щетку стеклоочистителя популярного премиум бренда HUOYE серии Y8,для автомобиля: Honda City 3A2\3A3 1996-2003 , Длина в мм: 600 400 , Длина в дюймах: 24" 16" , С адаптером типа: Данный комплект так-же подходит на следующие автомобили: BYD F3 3B 2005-2021, Changan Auchan A800 2017-, Changan Linmax 1 пок. 2017-, Chevrolet Captiva KL1C 2006-2015, Chevrolet Captiva C140\KL1C 2019-, Geely Emgrand EC7 1 пок. 2009-2020, Geely GC6 1 пок. 2014-2017, Great Wall Hover M4 2O12-2019, Haval M6 2 пок. 2021-, Haval M6 Plus 1 пок. 2021-, Honda City 3A2\3A3 1996-2003, Honda Civic EU\EN\ES\EP\EM 2000-2006, Hyundai Accent YC 2017-, Hyundai i20 PB 2008-2014, Hyundai i20 GB 2014-2020, Hyundai ix35 LM 2009-2017, Hyundai Solaris YC 2017-2022, Hyundai Tucson JM 2004-2009, Hyundai Tucson LM 2009-2015, JAC S5 1 пок. 2013-2021, Kia Cerato LD 2004-2008, Kia Rio YB\SC\FB 2016-, Kia Rio X 1 пок. 2017-2022, Kia Spectra LD 2004-2009, Kia Sportage JE\KM 2004-2010, Lifan 650 EV Breez HB\SD 520 2007-2012, Lifan Smily 330\320 2010-2017, Lifan Solano 630\620 2010-2016, Lifan Solano 650 2016-2022, Mazda Atenza GH 2008-2012, Mazda Demio DY 2002-2007, MG 3 X30 2008-2011, MG 3 ZP11 2010-2022, Renault Alaskan 1 пок. 2017-, Renault Scenic JA 1996-2003, Skoda Rapid NK3 Russia 2018-2019, Skywell ET5 1 пок. 2021-, Skywell HT-i 1 пок. 2023-, Subaru Impreza GE|GB\G12\GG\GH\GR\G22 2007-2012, Toyota Allex E120 2001-2006, Toyota Allion T240 2001-2007, Toyota Allion T260 2007-2021, Toyota Avensis T250 2002-2010, Toyota Caldina T210 1997-2002, Toyota Caldina T240 2002-2007, Toyota Corolla Fielder E120 2000-2006, Toyota Corolla Fielder E160 2012-, Toyota Premio T240 2001-2007, Toyota Premio T260 2007-2021, Toyota Prius NHW11\XW11\NHW10 1997-2003, Лада Гранта 1 пок. 2011-, Лада Гранта Кросс 1 пок. 2018-, Лада Гранта Спорт 1 пок. 2013-2018, Лада Калина 1 пок. 2004-2013, Лада Калина 2 пок. 2013-2018, Лада Калина Кросс 1 пок. 2014-2018, Лада Калина Спорт 1 пок. 2008-2014, Лада Калина Спорт 2 пок. 2014-2018
Technical Details
| Количество в наборе: | 2 |
| Страна производства: | Китай |
Price history chart & currency exchange rate
Customers also viewed

599.00 руб.
Блесна Mottomo FIRE BLADE № 1 (5гр) # 46 / Fluo, Зеленый;красный;серебристый, Fire blade
goods.ru
278.89 руб.
ocean series crab and clownfish silicone mold fondant cake silicone mold clay epoxy chocolate mold
fordeal.com
146,790.56 руб.
400W небольшой Электрический велосипед 48V20A литиевая батарея 70KM двухколесный велосипед для городских поездок
aliexpress.ru
483.37 руб.
Canvas Marvel Home Decoration Movie Wall Artwork Venom Painting Plastic Spider Man Hanging Scrolls Print Modern Picture Poster
aliexpress.ru
13,581.00 руб.
Туалетная вода Bvlgari, женская Rose Essentielle Eau De Toilette Rosee 50 мл
1st-original.ru
4,609.03 руб.
Xiaomi Mijia Youpin MSN Electric 3-blade Razor Men's Rechargeable Beard Knife Smart Washing Shaver Shaving Machine
aliexpress.com
29,887.56 руб.
New Arrival Women's Genuine Sheepskin Leather Jacket Top Quality Tuscan Wool Coats Winter Thick Warm S9033
aliexpress.com
280.00 руб.
Кабель USB 3.0 Cablexpert CCP-USB3-AMCM-1M (1м, USB3.0 AM/USB3.1 Type-C, пакет) (CCP-USB3-AMCM-1M)
kotofoto.ru
3,668.96 руб.
Brake Brake Thread Repair Kit For Vag Vw Vauxhall Ford Seat M9 x 1.25 Brake Caliper Guide Thread Repair Tool
aliexpress.com
2,254.40 руб.
Summer new fashion women's high heels wrapped ankle silk straps outdoor travel sandals non-slip thick bottom sandals women
aliexpress.com
15,584.37 руб.
Sugess Luxury st1901 Chronograph Movement Panda Dial Watch Men Sapphire 38mm Chronograph Mechanical Watch For Men montre homme
aliexpress.com
3,402.21 руб.
EMOSEWA Genuine Leather Shoes For Men's Breathable Trendy Soft-Soled Large Size 11 Casual Handmade Brand Moccasins Black Spring
aliexpress.com
16,397.54 руб.
sneaker women shoes leather trainer fashion sports shoes chaussures platform mens trainers triple espadrilles shoe10 px010, Black
dhgate.com
1,755.67 руб.
leather clutch wallet card holder zipper male wallets casual fashion long envelope travel bag
dhgate.com
1,066.17 руб.
ABS углеродное волокно, накладка на ручку переключения передач автомобиля для Volvo XC60 S60 V40 S80, модели 2013– 2017, обновление интерьера
aliexpress.ru